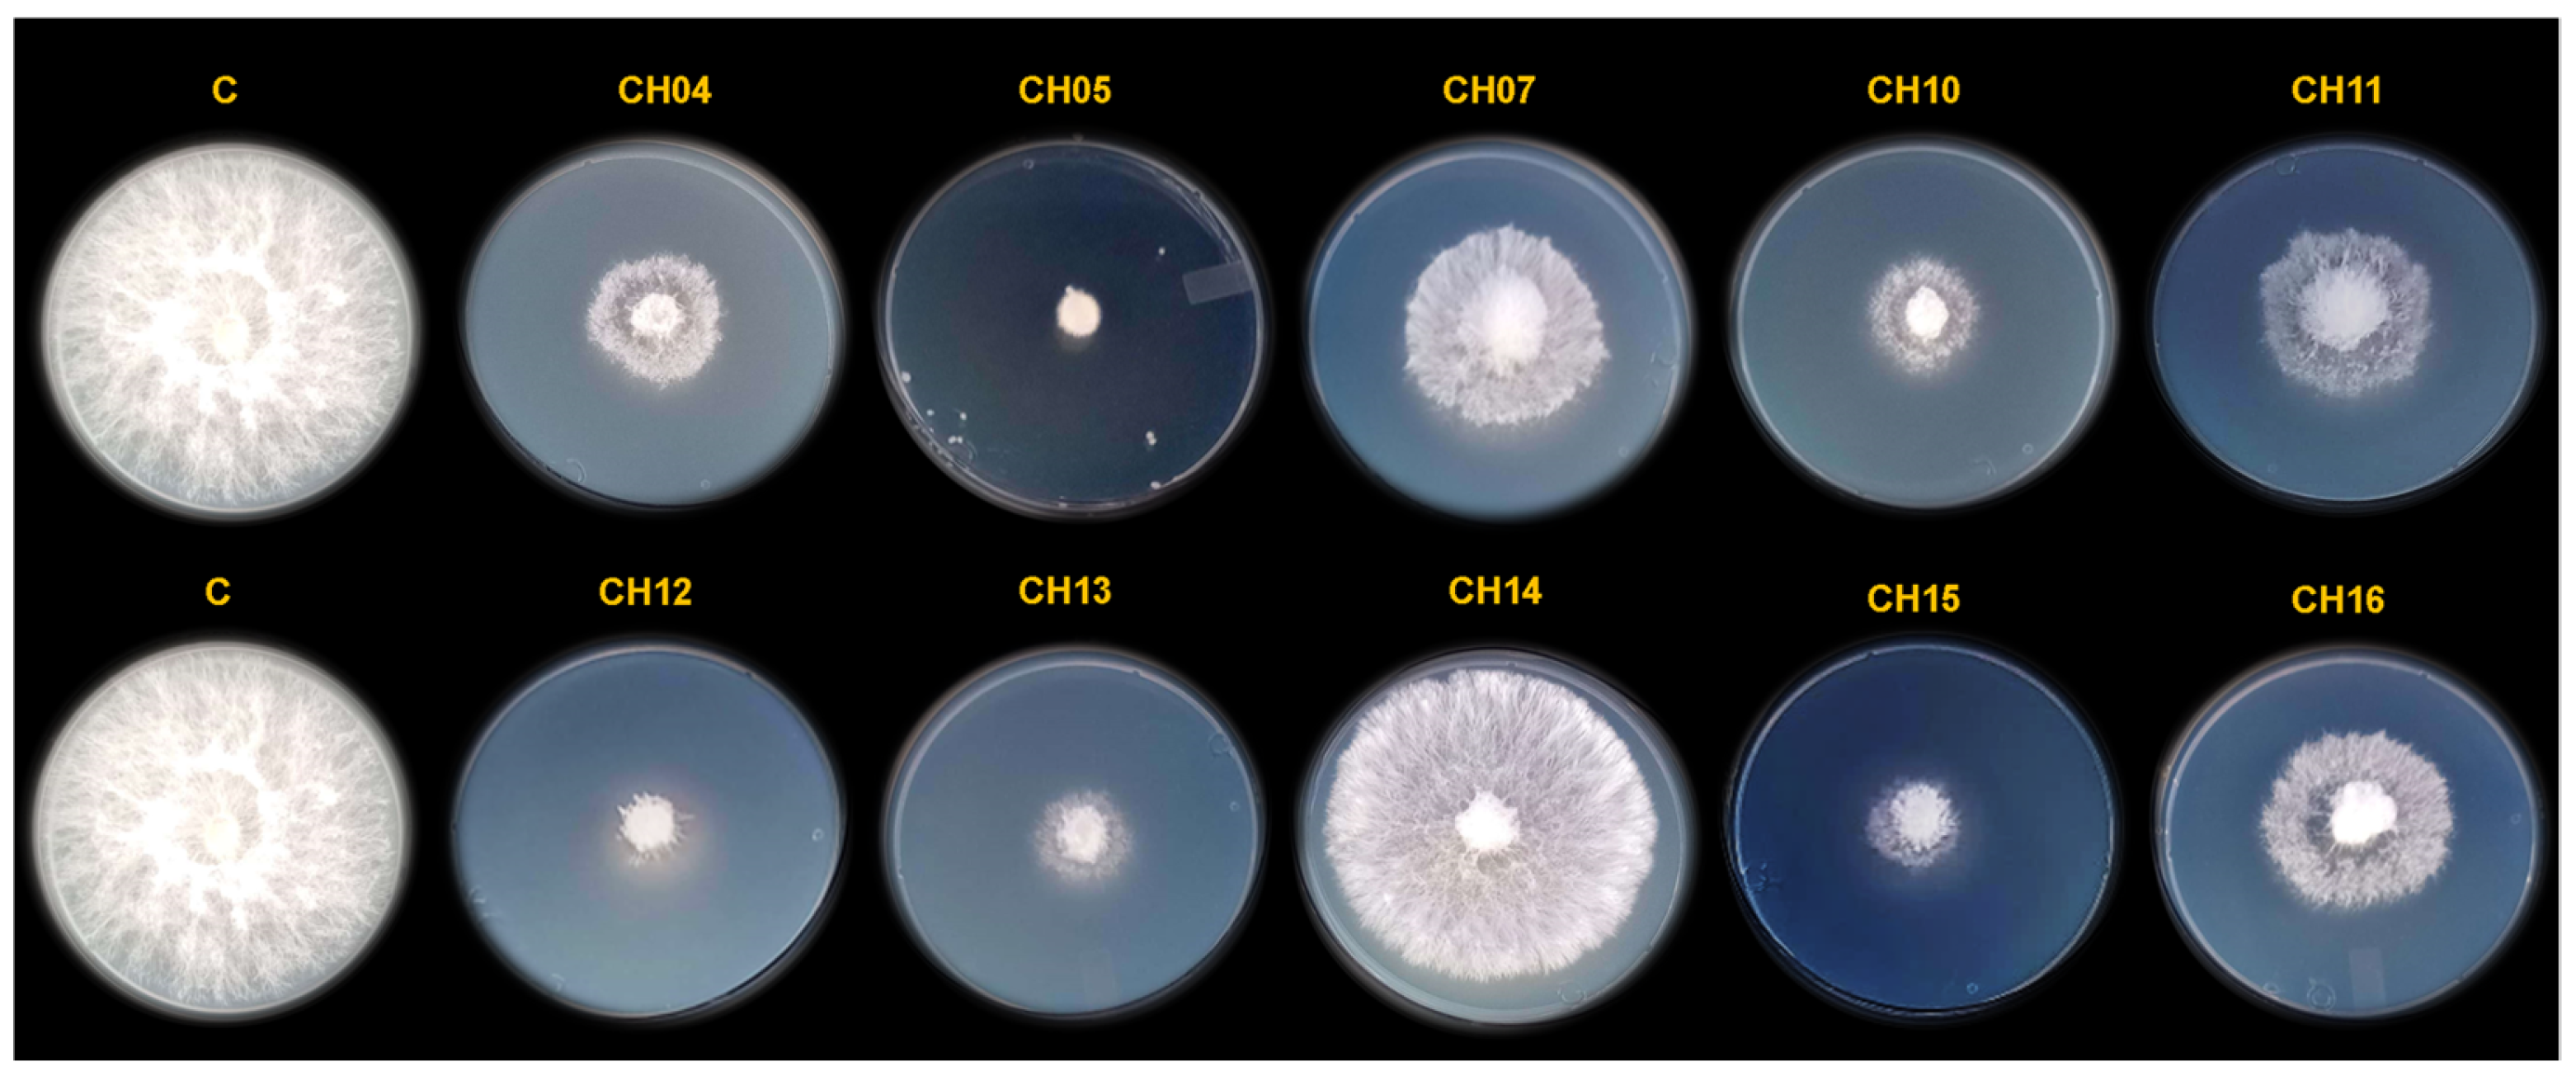
Microorganisms 12 01943 g002

Biocontrol Activity of Bacillus altitudinis CH05 and Bacillus tropicus CH13 Isolated from Capsicum annuum L. Seeds against Fungal Strains
Abstract
1. Introduction
2. Materials and Methods
2.1. Isolation of Capsicum spp. Seed-Surface-Associated Bacteria
2.2. Determination of the Antifungal Activity of Seed-Surface-Associated Bacteria In Vitro
2.3. Genome Sequencing, Assembly, and Annotation
2.4. Antibiotic Sensitivity
2.5. Analysis of VOCs Produced by B. altitudinis CH05 and B. tropicus CH13 via HS-SPME-GC-MS
2.6. Evaluation of Standard VOCs against Phytopathogenic Fungi
2.7. Statistical Analysis
3. Results
3.1. Isolation and Characterization of Seed-Surface-Associated Bacteria
3.2. Characterization of Bacterial Isolates CH05 and CH13 against Phytopathogenic Fungal Strains In Vitro
3.3. Genomic Analysis of B. altitudinis CH05 and B. tropicus CH13
3.4. Characterization of VOCs
3.5. Mycelial Growth Effects of Standard VOCs
4. Discussion
5. Conclusions
Supplementary Materials
Author Contributions
Funding
Data Availability Statement
Acknowledgments
Conflicts of Interest
References
- Kraft, K.H.; Brown, C.H.; Nabhan, G.P.; Luedeling, E.; Luna Ruiz, J.d.J.; Coppens d’Eeckenbrugge, G.; Hijmans, R.J.; Gepts, P. Multiple lines of evidence for the origin of domesticated chili pepper, Capsicum annuum, in Mexico. Proc. Natl. Acad. Sci. USA 2014, 111, 6165–6170. [Google Scholar] [CrossRef] [PubMed]
- Tripodi, P.; Rabanus-Wallace, M.T.; Barchi, L.; Kale, S.; Esposito, S.; Acquadro, A.; Schafleitner, R.; van Zonneveld, M.; Prohens, J.; Diez, M.J.; et al. Global range expansion history of pepper (Capsicum spp.) revealed by over 10,000 genebank accessions. Proc. Natl. Acad. Sci. USA 2021, 118, e2104315118. [Google Scholar] [CrossRef] [PubMed]
- Swamy, K.R.M. Origin, distribution, taxonomy, botanical description, genetic diversity and breeding of capsicum (Capsicum annuum L.). Int. J. Dev. Res. 2023, 13, 61956–61977. [Google Scholar]
- McCoy, J.; Martínez-Ainsworth, N.; Bernau, V.; Scheppler, H.; Hedblom, G.; Adhikari, A.; McCormick, A.; Kantar, M.; McHale, L.; Jardón-Barbolla, L.; et al. Population structure in diverse pepper (Capsicum spp.) accessions. BMC Res. Notes 2023, 16, 20. [Google Scholar] [CrossRef] [PubMed]
- Pereira-Dias, L.; Vilanova, S.; Fita, A.; Prohens, J.; Rodríguez-Burruezo, A. Genetic diversity, population structure, and rela tionships in a collection of pepper (Capsicum spp.) landraces from the Spanish centre of diversity revealed by genotyping-by sequencing (GBS). Hortic. Res. 2019, 6, 54. [Google Scholar] [CrossRef]
- Zhang, X.-M.; Zhang, Z.-H.; Gu, X.-Z.; Mao, S.-L.; Li, X.; Chadœuf, J.; Palloix, A.; Wang, L.-H.; Zhang, B.-X. Genetic diversity of pepper (Capsicum spp.) germplasm resources in China reflects selection for cultivar types and spatial distribution. J. Integr. Agric. 2016, 15, 1991–2001. [Google Scholar] [CrossRef]
- Market Reports World Global Capsicum Industry Research Report Competitive Landscape Market—Industry Reports. Available online: https://www.marketreportsworld.com/global-capsicum-industry-research-report-2023-competitive-landscape-market-22367246 (accessed on April 2024).
- Food and Agriculture Organization of the United Nations. FAOSTAT Statistics Database. 2021. Available online: https://www.fao.org/faostat/en/#data/QCL (accessed on 30 August 2021).
- Parisi, M.; Alioto, D.; Tripodi, P. Overview of Biotic Stresses in Pepper (Capsicum spp.): Sources of Genetic Resistance, Molecular Breeding and Genomics. Int. J. Mol. Sci. 2020, 21, 2587. [Google Scholar] [CrossRef] [PubMed] [PubMed Central]
- Shaheen, N.; Khan, U.M.; Azhar, M.T.; Tan, D.K.Y.; Atif, R.M.; Israr, M.; Yang, S.-H.; Chung, G.; Rana, I.A. Genetics and Genomics of FusariumWilt of Chilies: A Review. Agronomy 2021, 11, 2162. [Google Scholar] [CrossRef]
- Saxena, A.; Raghuwanshi, R.; Gupta, V.K.; Singh, H.B. Chilli Anthracnose: The Epidemiology and Management. Front. Microbiol. 2016, 7, 1527. [Google Scholar] [CrossRef] [PubMed] [PubMed Central]
- Kenyon, L.; Kumar, S.; Tsai, W.S.; Hughes, J.D. Virus diseases of peppers (Capsicum spp.) and their control. Adv. Virus Res. 2014, 90, 297–354. [Google Scholar] [CrossRef] [PubMed]
- Damicone, J.; Cevallos, F.; Trent, M.; Diaz, C.; Johnson, B.; Hubhachen, Z. Biology and Management of Bacterial Spot of Peppers in Oklahoma. Plant Dis. 2021, 105, 1129–1135. [Google Scholar] [CrossRef] [PubMed]
- Saxena, A.; Raghuvanshi, R.; Singh, H.B. Molecular, phenotypic and pathogenic variability in Colletotrichum isolates of subtropical region in North Eastern India, causing fruit rot of chillies. J. Appl. Microbiol. 2014, 117, 1422–1434. [Google Scholar] [CrossRef] [PubMed]
- Meghvansi, M.K.; Khan, M.H.; Gupta, R.; Veer, V. Identification of a new species of Cercospora causing leaf spot disease in Capsicum assamicum in northeastern India. Res. Microbiol. 2013, 164, 894–902. [Google Scholar] [CrossRef] [PubMed]
- Quesada-Ocampo, L.M.; Parada-Rojas, C.H.; Hansen, Z.; Vogel, G.; Smart, C.; Hausbeck, M.K.; Carmo, R.M.; Huitema, E.; Naegele, R.P.; Kousik, C.S.; et al. Phytophthora capsici: Recent Progress on Fundamental Biology and Disease Management 100 Years After Its Description. Annu. Rev. Phytopathol. 2023, 61, 185–208. [Google Scholar] [CrossRef] [PubMed]
- Hyder, S.; Gondal, A.S.; Rizvi, Z.F.; Atiq, R.; Haider, M.I.S.; Fatima, N.; Inam-ul-Haq, M. Biological Control of Chili Damping-Off Disease, Caused by Pythium myriotylum. Front. Microbiol. 2021, 12, 587431. [Google Scholar] [CrossRef]
- Wang, Z.; Ma, L.Y.; Cao, J.; Li, Y.L.; Ding, L.N.; Zhu, K.M.; Yang, Y.H.; Tan, X.L. Recent Advances in Mechanisms of Plant Defense to Sclerotinia sclerotiorum. Front. Plant Sci. 2019, 10, 1314. [Google Scholar] [CrossRef]
- Sabeena, B.; Ashtaputre, S.A. Estimation of Yield Loss Due to Powdery Mildew of Chilli Caused by Leveillula taurica (Lev) Arn. Int. J. Pure App. Biosci. 2019, 7, 323–326. [Google Scholar] [CrossRef]
- Ro, N.; Haile, M.; Hur, O.; Geum, B.; Rhee, J.; Hwang, A.; Kim, B.; Lee, J.; Hahn, B.-S.; Lee, J.; et al. Genome-Wide Association Study of Resistance to Phytophthora capsici in the Pepper (Capsicum spp.) Collection. Front. Plant Sci. 2022, 13, 902464. [Google Scholar] [CrossRef]
- Pimentão, A.R.; Cuco, A.P.; Pascoal, C.; Cássio, F.; Castro, B.B. Current trends and mismatches on fungicide use and assessment of the ecological effects in freshwater ecosystems. Environ. Pollut. 2024, 347, 123678. [Google Scholar] [CrossRef]
- Ma, G.; Gao, X.; Nan, J.; Zhang, T.; Xie, X.; Cai, Q. Fungicides alter the distribution and diversity of bacterial and fungal communities in ginseng fields. Bioengineered 2021, 12, 8043–8056. [Google Scholar] [CrossRef] [PubMed] [PubMed Central]
- Ayaz, M.; Li, C.H.; Ali, Q.; Zhao, W.; Chi, Y.K.; Shafiq, M.; Ali, F.; Yu, X.Y.; Yu, Q.; Zhao, J.T.; et al. Bacterial and Fungal Biocontrol Agents for Plant Disease Protection: Journey from Lab to Field, Current Status, Challenges, and Global Perspectives. Molecules 2023, 28, 6735. [Google Scholar] [CrossRef] [PubMed] [PubMed Central]
- Fira, D.; Dimkić, I.; Berić, T.; Lozo, J.; Stanković, S. Biological control of plant pathogens by Bacillus species. J. Biotechnol. 2018, 285, 44–55. [Google Scholar] [CrossRef] [PubMed]
- Albayrak, Ç.B. Bacillus Species as Biocontrol Agents for Fungal Plant Pathogens. In Bacilli and Agrobiotechnology: Phytostimulation and Biocontrol. Bacilli in Climate Resilient Agriculture and Bioprospecting; Islam, M., Rahman, M., Pandey, P., Boehme, M., Haesaert, G., Eds.; Springer: Cham, Switzerland, 2019. [Google Scholar] [CrossRef]
- Hasan, N.; Khan, I.U.; Farzand, A.; Heng, Z.; Moosa, A.; Saleem, M.; Canming, T. Bacillus altitudinis HNH7 and Bacillus velezensis HNH9 promote plant growth through upregulation of growth-promoting genes in upland cotton. J. Appl. Microbiol. 2022, 132, 3812–3824. [Google Scholar] [CrossRef] [PubMed]
- Hong, S.; Kim, T.Y.; Won, S.J.; Moon, J.H.; Ajuna, H.B.; Kim, K.Y.; Ahn, Y.S. Control of Fungal Diseases and Fruit Yield Improvement of Strawberry Using Bacillus velezensis CE 100. Microorganisms 2022, 10, 365. [Google Scholar] [CrossRef]
- Shimomura, Y.; Kawada, T.; Suzuki, M. Capsaicin and its analogs inhibit the activity of NADH-coenzyme Q oxidoreductase of the mitochondrial respiratory chain. Arch. Biochem. Biophys. 1989, 270, 573–577. [Google Scholar] [CrossRef]
- Yagi, T. Inhibition by capsaicin of NADH-quinone oxidoreductases is correlated with the presence of energy-coupling site 1 in various organisms. Arch. Biochem. Biophys. 1990, 281, 305–311. [Google Scholar] [CrossRef]
- O’Donnell, A.; Harvey, L.M.; McNeil, B. The roles of the alternative NADH dehydrogenases during oxidative stress in cultures of the filamentous fungus Aspergillus niger. Fungal Biol. 2011, 115, 359–369. [Google Scholar] [CrossRef]
- Marcet-Houben, M.; Marceddu, G.; Gabaldón, T. Phylogenomics of the oxidative phosphorylation in fungi reveals extensive gene duplicationfollowed by functional divergence. BMC Evol. Biol. 2009, 9, 295. [Google Scholar] [CrossRef]
- Kerscher, S.J.; Okun, J.G.; Brandt, U. A single external enzyme confers alternative NADH:ubiquinone oxidoreductase activity in Yarrowia lipolytica. J. Cell Sci. 1999, 112 Pt 14, 2347–2354. [Google Scholar] [CrossRef]
- Carneiro, P.; Duarte, M.; Videira, A. The external alternative NAD(P)H dehydrogenase NDE3 is localized both in the mitochondria and in the cytoplasm of Neurospora crassa. J. Mol. Biol. 2007, 368, 1114–1121. [Google Scholar] [CrossRef]
- Lee, M.; Cho, J.-Y.; Lee, Y.G.; Lee, H.J.; Lim, S.-I.; Park, S.-L.; Moon, J.-H. Bioconversion of capsaicin by Aspergillus oryzae. J. Agric. Food Chem. 2015, 63, 6102–6108. [Google Scholar] [CrossRef] [PubMed]
- Cho, S.; Moon, H.-I.; Hong, G.-E.; Lee, C.-H.; Kim, J.-M.; Kim, S.-K. Biodegradation of capsaicin by Bacillus licheniformis SK1230. J. Korean Soc. Appl. Biol. Chem. 2014, 57, 335–339. [Google Scholar] [CrossRef]
- Adams, C.A.; Zimmerman, K.; Fenstermacher, K.; Thompson, M.G.; Skyrud WBehie, S.; Pringle, A. Fungal seed pathogens of wild chili peppers possess multiple mechanisms to tolerate capsaicinoids. Appl. Environ. Microbiol. 2020, 86, e01697-19. [Google Scholar] [CrossRef] [PubMed]
- Hernández Flores, J.L.; Martínez, Y.J.; Ramos López, M.Á.; Saldaña Gutierrez, C.; Reyes, A.A.; Armendariz Rosales, M.M.; Cortés Pérez, M.J.; Mendoza, M.F.; Ramírez Ramírez, J.; Zavala, G.R.; et al. Volatile Organic Compounds Produced by Kosakonia cowanii Cp1 Isolated from the Seeds of Capsicum pubescens R & P Possess Antifungal Activity. Microorganisms 2023, 11, 2491. [Google Scholar] [CrossRef]
- Mena Navarro, M.P.; Espinosa Bernal, M.A.; Martinez-Avila, A.E.; Aponte Pineda, L.S.; Montes Flores, L.A.; Chan Ku, C.D.; Hernández Gómez, Y.F.; González Espinosa, J.; Pacheco Aguilar, J.R.; Ramos López, M.Á.; et al. Role of Volatile Organic Compounds Produced by Kosakonia cowanii Cp1 during Competitive Colonization Interaction against Pectobacterium aroidearum SM2. Microorganisms 2024, 12, 930. [Google Scholar] [CrossRef]
- Olson, R.D.; Assaf, R.; Brettin, T.; Conrad, N.; Cucinell, C.; Davis, J.J.; Dempsey, D.M.; Dickerman, A.; Dietrich, E.M.; Kenyon, R.W.; et al. Introducing the Bacterial Viral Bioinformatics Resource Center (BV-BRC): A resource combining PATRIC, IRD and ViPR. Nucleic Acids Res. 2022, 51, D678–D689. [Google Scholar]
- Bankevich, A.; Nurk, S.; Antipov, D.; Gurevich, A.A.; Dvorkin, M.; Kulikov, A.S.; Lesin, V.M.; Nikolenko, S.I.; Pham, S.; Prjibelski, A.D.; et al. SPAdes: A new genome assembly algorithm and its applications to single-cell sequencing. J. Comput. Biol. 2012, 19, 455–477. [Google Scholar] [CrossRef]
- Brettin, T.; Davis, J.J.; Disz, T.; Edwards, R.A.; Gerdes, S.; Olsen, G.J.; Olson, R.; Overbeek, R.; Parrello, B.; Pusch, G.D.; et al. RASTtk: A modular and extensible implementation of the RAST algorithm for building custom annotation pipelines and annotating batches of genomes. Sci. Rep. 2015, 5, 8365. [Google Scholar] [CrossRef]
- Grant, J.R.; Enns, E.; Marinier, E.; Mandal, A.; Herman, E.K.; Chen, C.-Y.; Graham, M.; Van Domselaar, G.; Stothard, P. Proksee:In-depth characterization and visualization of bacterial genomes. Nucleic Acids Res. 2023, 51, W484–W492. [Google Scholar] [CrossRef]
- Ondov, B.D.; Treangen, T.J.; Melsted, P.; Mallonee, A.B.; Bergman, N.H.; Koren, S.; Phillippy, A.M. Mash: Fast genome and metagenome distance estimation using MinHash. Genome Biol. 2016, 17, 132. [Google Scholar] [CrossRef]
- Kumar, S.; Stecher, G.; Li, M.; Knyaz, C.; Tamura, K. MEGA X: Molecular Evolutionary Genetics Analysis across Computing Platforms. Mol. Biol. Evol. 2018, 35, 1547–1549. [Google Scholar] [CrossRef]
- Stamatakis, A. RAxML version 8: A tool for phylogenetic analysis and post-analysis of large phylogenies. Bioinformatics 2014, 30, 1312–1313. [Google Scholar] [CrossRef] [PubMed]
- Richter, M.; Rosselló-Móra, R.; Oliver Glöckner, F.O.; Peplies, J. JSpeciesWS: A web server for prokaryotic species circumscription based on pairwise genome comparison. Bioinformatics 2015, 32, 929–931. [Google Scholar] [CrossRef] [PubMed]
- Clinical and Laboratory Standards Institute. Performance Standards for Antimicrobial Disk Susceptibility Tests, Approved Standard, 12th ed.; Clinical and Laboratory Standards Institute: Wayne, PA, USA, 2018. [Google Scholar]
- Grahovac, J.; Pajčin, I.; Vlajkov, V. Bacillus VOCs in the Context of Biological Control. Antibiotics 2023, 12, 581. [Google Scholar] [CrossRef] [PubMed] [PubMed Central]
- Fu, X.; Gong, L.; Liu, Y.; Lai, Q.; Li, G.; Shao, Z. Bacillus pumilus Group Comparative Genomics: Toward Pangenome Features, Diversity, and Marine Environmental Adaptation. Front. Microbiol. 2021, 12, 571212. [Google Scholar] [CrossRef] [PubMed]
- Zeng, Q.; Xie, J.; Li, Y.; Gao, T.; Zhang, X.; Wang, Q. Comprehensive Genomic Analysis of the Endophytic Bacillus altitudinis Strain GLB197, a Potential Biocontrol Agent of Grape Downy Mildew. Front. Genet. 2021, 12, 729603. [Google Scholar] [CrossRef]
- Lu, X.; Zhou, D.; Chen, X.; Zhang, J.; Huang, H.; Wei, L. Isolation and characterization of Bacillus altitudinis JSCX-1 as a new potential biocontrol agent against Phytophthora sojae in soybean [Glycine max (L.) Merr.]. Plant Soil 2017, 416, 53–66. [Google Scholar] [CrossRef]
- Shan, Y.; Wang, D.; Zhao, F.H.; Song, J.; Zhu, H.; Li, Y.; Zhang, X.J.; Dai, X.F.; Han, D.; Chen, J.Y. Insights into the biocontrol and plant growth promotion functions of Bacillus altitudinis strain KRS010 against Verticillium dahliae. BMC Biol. 2024, 22, 116. [Google Scholar] [CrossRef]
- Malik, J.; Moosa, A.; Zulfiqar, F.; Aslam, M.N.; Albalawi, M.A.; Almowallad, S.; Mahmood, T.; Alasmari, A.; Yong, J.W.H. Biocontrol potential of lipopeptides produced by the novel Bacillus altitudinis strain TM22A against postharvest Alternaria rot of tomato. LWT-Food Sci. Technol. 2024, 191, 115541. [Google Scholar] [CrossRef]
- Wu, Y.; Tan, Y.; Peng, Q.; Xiao, Y.; Xie, J.; Li, Z.; Ding, H.; Pan, H.; Wei, L. Biocontrol potential of endophytic bacterium Bacillus altitudinis GS-16 against tea anthracnose caused by Colletotrichum gloeosporioides. PeerJ 2024, 12, e16761. [Google Scholar] [CrossRef]
- Sarmah, P.P.; Nath, H.K.D.; Nath, T. Endophytic Bacillus spp. from native chilli cultivars and their effect against fruit rot pathogen of Bhut Jolokia (Capsicum chinense Jacq.). Egypt. J. Biol. Pest Control 2023, 33, 119. [Google Scholar] [CrossRef]
- Liu, Y.; Du, J.; Lai, Q.; Zeng, R.; Ye, D.; Xu, J.; Shao, Z. Proposal of nine novel species of the Bacillus cereus group. Int. J. Syst. Evol. Microbiol. 2017, 67, 2499–2508, Erratum in Int. J. Syst. Evol. Microbiol. 2018, 68, 2706. [Google Scholar] [CrossRef] [PubMed]
- Carroll, L.M.; Cheng, R.A.; Wiedmann, M.; Kovac, J. Keeping up with the Bacillus cereus group: Taxonomy through the genomics era and beyond. Crit. Rev. Food Sci. Nutr. 2021, 62, 7677–7702. [Google Scholar] [CrossRef] [PubMed]
- Kulkova, I.; Dobrzyński, J.; Kowalczyk, P.; Bełzecki, G.; Kramkowski, K. Plant Growth Promotion Using Bacillus cereus. Int. J. Mol. Sci. 2023, 24, 9759. [Google Scholar] [CrossRef] [PubMed]
- Zhou, H.; Ren, Z.-H.; Zu, X.; Yu, X.-Y.; Zhu, H.-J.; Li, X.-J.; Zhong, J.; Liu, E.-M. Efficacy of Plant Growth-Promoting Bacteria Bacillus cereus YN917 for Biocontrol of Rice Blast. Front. Microbiol. 2021, 12, 684888. [Google Scholar] [CrossRef] [PubMed]
- Hu, J.; Dong, B.; Wang, D.; Meng, H.; Li, X.; Zhou, H. Genomic and metabolic features of Bacillus cereus, inhibiting the growth of Sclerotinia sclerotiorum by synthesizing secondary metabolites. Arch. Microbiol. 2023, 205, 8. [Google Scholar] [CrossRef] [PubMed]
- Xiong, Z.; Jiang, Y.; Qi, D.; Lu, H.; Yang, F.; Yang, J.; Chen, L.; Sun, L.; Xu, X.; Xue, Y.; et al. Complete genome sequence of the extremophilic Bacillus cereus strain Q1 with industrial applications. J. Bacteriol. 2009, 191, 1120–1121. [Google Scholar] [CrossRef] [PubMed][Green Version]
- Fatima, H.; Kumar, S.; Khare, S.K. Insights from the genome sequence of Bacillus tropicus EMB20, an efficient β-lactamase-producing bacterium. 3 Biotech. 2022, 12, 330. [Google Scholar] [CrossRef]
- Shen, N.; Yang, M.; Xie, C.; Pan, J.; Pang, K.; Zhang, H.; Wang, Y.; Jiang, M. Isolation and identification of a feather degrading Bacillus tropicus strain Gxun-17 from marine environment and its enzyme characteristics. BMC Biotechnol. 2022, 22, 11. [Google Scholar] [CrossRef]
- Aregbesola, O.A.; Kumar, A.; Mokoena, M.P.; Olaniran, A.O. Whole-genome sequencing, genome mining, metabolic reconstruction and evolution of pentachlorophenol and other xenobiotic degradation pathways in Bacillus tropicus strain AOA-CPS1. Funct. Integr. Genom. 2021, 21, 171–193. [Google Scholar] [CrossRef]
- Ibrahim, N.E.; Sevakumaran, V.; Ariffin, F. Preliminary study on glyphosate-degrading bacteria isolated from agricultural soil. Environ. Adv. 2023, 12, 100368. [Google Scholar] [CrossRef]
- Samanta, S.; Datta, D.; Halder, G. Biodegradation efficacy of soil inherent novel sp. Bacillus tropicus (MK318648) onto low density polyethylene matrix. J. Polym. Res. 2020, 27, 324. [Google Scholar] [CrossRef]
- Tsai, J.-M.; Kuo, H.-W.; Cheng, W. Retrospective Screening of Anthrax-like Disease Induced by Bacillus tropicus str. JMT from Chinese Soft-Shell Turtles in Taiwan. Pathogens 2023, 12, 693. [Google Scholar] [CrossRef] [PubMed]
- Pawaskar, M.; Kerkar, S. Microbial biocontrol agents against chilli plant pathogens over synthetic pesticides: A review. Proc. Indian Natl. Sci. Acad. 2021, 87, 578–594. [Google Scholar] [CrossRef]
- Sam-on, M.F.S.; Mustafa, S.; Yusof, M.T.; Hashim, A.M.; Aizuddin, K.N.A.K. Exploring the Global Trends of Bacillus, Trichoderma and Entomopathogenic Fungi for Pathogen and Pest Control in Chili Cultivation. Saudi J. Biol. Sci. 2024, 31, 104046. [Google Scholar] [CrossRef] [PubMed]
- Zou, X.; Ning, J.; Zhao, X.; Lv, H.; Qin, N.; Yin, H.; Ren, L. Bacillus velezensis LY7 promotes pepper growth and induces resistance to Colletotrichum scovillei. Biol. Control 2024, 192, 105480. [Google Scholar] [CrossRef]
- Kumar, A.; Rabha, J.; Jha, D.K. Antagonistic activity of lipopeptide-biosurfactant producing Bacillus subtilis AKP, against Colletotrichum capsici, the causal organism of anthracnose disease of chilli. Biocatal. Agric. Biotechnol. 2021, 36, 102133. [Google Scholar] [CrossRef]
- Montoya-Martínez, A.C.; Figueroa-Brambila, K.M.; Escalante-Beltrán, A.; López-Montoya, N.D.; Valenzuela-Ruíz, V.; Parra-Cota, F.I.; Estrada Alvarado, M.I.; de los Santos-Villalobos, S. Biological Control Mechanisms of Bacillus cabrialesii subsp. tritici TSO2T against Fusarium languescens, the Causal Agent of Wilt in Jalapeño Peppers. Horticulturae 2023, 9, 964. [Google Scholar] [CrossRef]
- Qiao, J.; Zhang, R.; Liu, Y.; Liu, Y. Evaluation of the Biocontrol Efficiency of Bacillus subtilis Wettable Powder on Pepper Root Rot Caused by Fusarium solani. Pathogens 2023, 12, 225. [Google Scholar] [CrossRef]
- Zhao, X.; Zhou, J.; Tian, R.; Liu, Y. Microbial volatile organic compounds: Antifungal mechanisms, applications, and challenges. Front. Microbiol. 2022, 13, 922450. [Google Scholar] [CrossRef]
- Xiao, Z.; Lu, J.R. Strategies for enhancing fermentative production of acetoin: A review. Biotechnol. Adv. 2014, 32, 492–503. [Google Scholar] [CrossRef]
- Saini, M.; Anu; Rapoport, A.; Tiwari, S.K.; Singh, D.; Malik, V.; Kumar, S.; Singh, B. Bioacetoin Production by Bacillus subtilis subsp. subtilis Using Enzymatic Hydrolysate of Lignocellulosic Biomass. Fermentation 2023, 9, 698. [Google Scholar] [CrossRef]
- Kumar, A.; Solanki, M.K.; Wang, Z.; Solanki, A.C.; Singh, V.K.; Divvela, P.K. Revealing the seed microbiome: Navigating sequencing tools, microbial assembly, and functions to amplify plant fitness. Microbiol. Res. 2024, 279, 127549. [Google Scholar] [CrossRef] [PubMed]
- Niza-Costa, M.; Rodríguez-dos Santos, A.S.; Rebelo-Romão, I.; Ferrer, M.V.; Sequero López, C.; Vílchez, J.I. Geographically Disperse, Culturable Seed-Associated Microbiota in Forage Plants of Alfalfa (Medicago sativa L.) and Pitch Clover (Bituminaria bituminosa L.): Characterization of Beneficial Inherited Strains as Plant Stress-Tolerance Enhancers. Biology 2022, 11, 1838. [Google Scholar] [CrossRef] [PubMed]
- War, A.F.; Bashir, I.; Reshi, Z.A.; Kardol, P.; Rashid, I. Insights into the seed microbiome and its ecological significance in plant life. Microbiol. Res. 2023, 269, 127318. [Google Scholar] [CrossRef]

| Chili Cultivar | Specie | Region | Number of Bacterial Isolates |
|---|---|---|---|
| Serrano | Capsicum annuum L. | Querétaro | 9 |
| Jalapeño | Capsicum annuum L. | Querétaro | 2 |
| Pimiento | Capsicum annuum L. | Querétaro | 2 |
| Poblano | Capsicum annuum L. | Querétaro | 3 |
| Habanero | Capsicum chinense | Querétaro | 5 |
| Poblano | Capsicum annuum L. | Michoacán | 5 |
| Jalapeño | Capsicum annuum L. | Michoacán | 7 |
| Manzano | Capsicum pubescens | Michoacán | 8 |
| Píquin | Capsicum annuum L. | Michoacán | 3 |
| Serrano | Capsicum annuum L. | Michoacán | 6 |
| Habanero | Capsicum chinense | Michoacán | 3 |
| Húngaro | Capsicum annuum L. | Michoacán | 9 |
| Chilaca | Capsicum annuum L. | Michoacán | 8 |
| Habanero | Capsicum chinense | Yucatán | 2 |
| Húngaro | Capsicum annuum L. | Yucatán | 1 |
| Dulce | Capsicum annuum L. | Yucatán | 3 |
| Characteristics | Source | B. altitudinis CH05 | B. tropicus CH13 |
|---|---|---|---|
| Genome length (bp) | PATRIC | 3,687,876 bp | 5,283,743 bp |
| Contigs | PATRIC | 18 | 54 |
| Proteins with functional assignments | PATRIC | 3050 | 4265 |
| Hypothetical proteins | PATRIC | 844 | 1243 |
| rRNA | PATRIC | 3 | 4 |
| tRNA | PATRIC | 68 | 73 |
| Proteins with pathway assignments | KEGG | 683 | 830 |
| GC content | PATRIC | 41.25% | 35.24% |
| N50 length (bp) | PATRIC | 973,713 | 381,948 |
| Virulence factors | Victors | 2 | 12 |
| Virulence factors | VFDB | 0 | 9 |
| Antibiotic resistance | PATRIC | 40 | 48 |
| Antibiotic resistance | CARD | 2 | 7 |
| Antibiotic resistance | NDARO | 2 | 5 |
| Transporters | TCDB | 65 | 52 |
Disclaimer/Publisher’s Note: The statements, opinions and data contained in all publications are solely those of the individual author(s) and contributor(s) and not of MDPI and/or the editor(s). MDPI and/or the editor(s) disclaim responsibility for any injury to people or property resulting from any ideas, methods, instructions or products referred to in the content. |
© 2024 by the authors. Licensee MDPI, Basel, Switzerland. This article is an open access article distributed under the terms and conditions of the Creative Commons Attribution (CC BY) license (https://creativecommons.org/licenses/by/4.0/).
Share and Cite
Espinosa Bernal, M.A.; Mena Navarro, M.P.; Arvizu Gómez, J.L.; Saldaña, C.; Ramos López, M.Á.; Amaro Reyes, A.; Escamilla García, M.; Pacheco Aguilar, J.R.; Moreno, V.P.; Rodríguez Morales, J.A.; et al. Biocontrol Activity of Bacillus altitudinis CH05 and Bacillus tropicus CH13 Isolated from Capsicum annuum L. Seeds against Fungal Strains. Microorganisms 2024, 12, 1943. https://doi.org/10.3390/microorganisms12101943
Espinosa Bernal MA, Mena Navarro MP, Arvizu Gómez JL, Saldaña C, Ramos López MÁ, Amaro Reyes A, Escamilla García M, Pacheco Aguilar JR, Moreno VP, Rodríguez Morales JA, et al. Biocontrol Activity of Bacillus altitudinis CH05 and Bacillus tropicus CH13 Isolated from Capsicum annuum L. Seeds against Fungal Strains. Microorganisms. 2024; 12(10):1943. https://doi.org/10.3390/microorganisms12101943
Chicago/Turabian StyleEspinosa Bernal, Merle Ariadna, Mayra Paola Mena Navarro, Jackeline Lizzeta Arvizu Gómez, Carlos Saldaña, Miguel Ángel Ramos López, Aldo Amaro Reyes, Monserrat Escamilla García, Juan Ramiro Pacheco Aguilar, Victor Pérez Moreno, José Alberto Rodríguez Morales, and et al. 2024. "Biocontrol Activity of Bacillus altitudinis CH05 and Bacillus tropicus CH13 Isolated from Capsicum annuum L. Seeds against Fungal Strains" Microorganisms 12, no. 10: 1943. https://doi.org/10.3390/microorganisms12101943
APA StyleEspinosa Bernal, M. A., Mena Navarro, M. P., Arvizu Gómez, J. L., Saldaña, C., Ramos López, M. Á., Amaro Reyes, A., Escamilla García, M., Pacheco Aguilar, J. R., Moreno, V. P., Rodríguez Morales, J. A., Álvarez Hidalgo, E., Nuñez Ramírez, J., Hernández Flores, J. L., & Campos Guillén, J. (2024). Biocontrol Activity of Bacillus altitudinis CH05 and Bacillus tropicus CH13 Isolated from Capsicum annuum L. Seeds against Fungal Strains. Microorganisms, 12(10), 1943. https://doi.org/10.3390/microorganisms12101943

